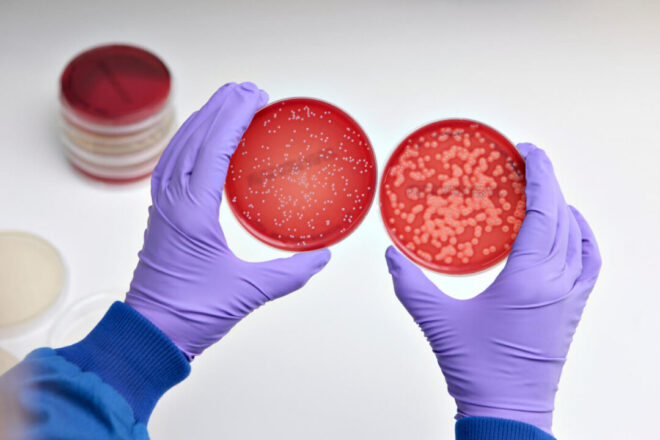

Стафилококк (Staphylococcus aureus) – грамположительная условно-патогенная бактерия, распространенная повсеместно. В норме золотистый стафилококк может находиться у человека на слизистой оболочке носа, в брюшной полости и на коже.
Попав в организм человека, патогенный стафилококк вырабатывает токсины и может стать источником сепсиса при снижении иммунитета, вызывая генерализованные инфекции с очагами воспаления во внутренних органах, коже и костно-мышечной системе.
Основные источники инфекции: здоровые (носители) и больные люди, домашние и сельскохозяйственные животные, а также пища, содержащая патогенный стафилококк и его мощные токсины (чаще всего это сахаросодержащие молочные продукты, мороженное, кондитерские изделия без термообработки, салаты и т.п.).
Дети могут инфицироваться от взрослых стафолококконосителей. У детей грудного возраста возможно выделение стафилококка в посевах фекалий.
В эпидемиологических целях анализ на выявление патогенного стафилококка обязательно проводят во время ежегодных профилактических осмотров и при предварительных осмотрах для приема на работу в сферы обслуживания населения: медицины, образования, питания, торговли и т.п. Чаще, посев выполняется из носа и зева.
Наличие золотистого стафилококка не обязательно означает инфекцию, это может быть бессимптомное носительство, например, при посеве мазков из носа и зева носительством считается количество бактерий до 103КОЕ. Однако более высокие показатели говорят о том, что это уже не бессимптомное носительство, а то, что выявленный золотистый стафилококк может являться причиной заболевания.
В каких случаях назначают посев на золотистый стафилококк?
- Для выяснения бактерионосительства или опасного инфицирования.
- Для подтверждения, что стафилококк является причиной возникшего заболевания (об этом свидетельствуют высокие показатели посева).
- Для определения целесообразности лечения.
- Для контроля за состоянием пациента после проведенного лечения.
Что означают результаты анализа?
В норме результат – «отрицательный», микроорганизм (Staphylococcus aureus) не обнаружен.
«Положительный» результат – выявление золотистого стафилококка, свидетельствует об инфекции или о бессимптомном носительстве. При выявлении роста Staphylococcus aureus, тактику лечения определяет врач.
Исследование можно пройти по направлению от лечащего врача вашей поликлиники, если есть клинические показания, либо на платной основе в лаборатории «Национальный центр экспертизы» Аккольского района.
Лаборант-бактериолог Бекмагамбетова К.А.
